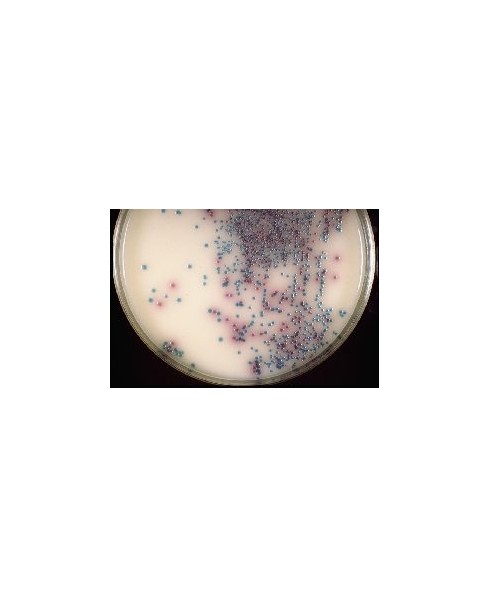

Le immagini sono puramente indicative
-
Prodotti
- Prodotti
-
Strumentazione
- Strumentazione
- agitatori
- autoclavi
- armadi di sicurezza
- bagnomaria
- bioluminometri
- b.o.d.
- bilance
- burette digitali dispensatrici
- camere climatiche
- campionatori d'aria
- cappe
- centrifughe
- chiller
- conduttimetri
- congelatori
- contacolonie
- contenitori criobiologici
- criostati
- data logger
- digestori e distillatori azoto
- diluitori
- estrazione
- evaporatori
- fabbricatori di ghiaccio
- flocculatori, jar test e test di cessione
- forni
- frigoriferi
- igrometri
- incubatori
- lampade uv
- lavavetrerie e detergenti
- liofilizzatori
- mantelli riscaldanti
- microscopi
- misuratori multiparametro
- mulini
- omogeneizzatori
- ossimetri
- phmetri
- polarimetri
- pompe
- punto fusione
- rifrattometri
- sanitizzazione ambientale
- setacciatori
- sistemi di purificazione acqua
- sonicatori
- spettrofotometri
- strumenti per micropiastre
- stufe
- termoblocchi
- termometri
- termoreattori micro-macro c.o.d.
- termosigillatrici
- titolatori
- torbidimetri
- transilluminatori
- viscosimetri
- piastre riscaldanti
- fotometri e densitometri per biologia
- sterilizzatori
- vasche ad ultrasuoni
-
Vetreria
- Vetreria
- agitatori in vetro
- apparecchiature in vetro
- beute
- bicchieri cilindrici
- bottiglie contagocce
- bottiglie tappo smerigliato
- bottiglie tappo a vite
- bottiglie per b.o.d.
- bottiglie drechsel lavaggio gas
- burette caricamento automatico
- burette caricamento manuale
- capillari
- capsule
- cilindri
- colonne di vigreux
- coni imhoff
- cristallizzatori
- crogioli filtranti
- cromatografia
- cuvette per spettrofotometria
- essiccatori
- estrattori soxhlet
- gorgogliatori
- imbuti
- imbuti separatori
- lampade ad alcol
- matracci tarati
- mortai
- navicelle per pesata
- omogeneizzatori tipo potter
- palline di vetro
- palloni
- pesafiltri
- piastre petri
- picnometri
- pipette pasteur
- pipette graduate a volume
- pipette tarate
- pompe da vuoto in vetro
- provette cilindriche
- provette disposable per coltura
- provette coniche per centrifuga
- raccordi
- refrigeranti
- rubinetti in vetro
- tappi plastica filettatura a vite
- tappi vetro soffiato
- tubi
- vetri orologio
- vial e rack
- viscosimetri
-
Termometri/Densimetri
-
Porcellana e Quarzo
-
Pinze/Morsetti/Bunsen
- Pinze/Morsetti/Bunsen
- aste per agitazione
- cestelli in rete
- coltelli
- coppa di ford
- fascette stringitubo
- foratappi a mano
- forbici
- forcella portalampada
- morsetti
- piastre ceran in vetroceramica
- pinze
- pinze stringitubo
- portaprovette
- pompe per vuoto in metallo
- reticelle spargifiamma
- sostegni
- spatole
- spazzolini
- triangoli per crogioli
- tubi per sterilizzare pipette
- lampade bunsen
-
Filtrazione
- Filtrazione
- carta da filtro qualitativa
- carta da filtro quantitativa
- carta per usi particolari
- carte cromatografiche
- membrane filtranti
- filtri in fibra
-
filtri siringa
- FILTRI SIRINGA
- Vedi tutti
- acetato di cellulosa
- cellulosa rigenerata
- nylon
- pes (polietersulfone)
- ptfe
- pvdf
- whatman anotop - membrana inorganica
- whatman gd/x - con prefiltro multistrato
- whatman puradisc - vari materiali
- whatman spartan - certificati per hplc
- whatman uniflo - vari materiali
- supporti per membrane per siringa
- filtri speciali
- sistemi filtranti e articoli per microbiologia
- carte e membrane per blotting
-
Plastica Riutilizzabile
- Plastica Riutilizzabile
- agitatori
- aste magnetizzate pvc
- ancorette magnetiche
- bacinelle
- bicchieri cilindrici
- bicchieri conici
- bottiglie cilindriche
- bottiglie rettangolari
- bottiglie a spruzzetta
- bottiglioni
- burette
- capsule in ptfe
- caraffe graduate
- cilindri graduati
- cilindri per pipette
- coni imhoff
- contenitori con tappo
- cristallizzatori in ptfe
- essiccatori
- etichette
- frigobox
- guaine per coni di vetro
- imbuti in polipropilene
- lavapipette e accessori
- matracci conici (beute)
- matracci tarati con tappo a vite
- matracci tarati con tappo conico
- nastro in ptfe
- pesafiltri
- pinze per burette
- pompe
- portapipette
- portaprovette - rack
- provette per centrifuga
- raccordi per tubi
- rilevatori di flusso
- rubinetti di intercettazione
- scolavetrerie
- sessole
- spatole per laboratorio
- supporti per palloni
- tappi
- valvole di arresto per vuoto
- vasi cilindrici con tappo
- vetri da orologio
-
Plastica Monouso e accessori
- Plastica Monouso e accessori
- bacchette
- box di stoccaggio
- box per campioni refrigerati
- contenitori portacampioni
- cryovials
- cuvette e contaglobuli
- microprovette
- micrewtube
- piastre per microbiologia
- micropiastre
- pipette pasteur
- pipette per sierologia
- plastica per colture cellulari
- prodotti per la pcr®
- provette
- unita' di filtrazione sotto vuoto monouso
- vials per scintillazione liquidi
-
Accessori per pHmetria
- Accessori per pHmetria
- accessori per phmetri
- elettrodi ph hach
- elettrodi di ph hamilton
- elettrodi di ph xs sensor
- elettrodi metallici
- elettrodi iono selettivi (i.s.e.)
- soluzioni tampone ph
- soluzioni standard di conducibilità
- soluzioni varie
- tester tascabili
- cartine indicatrici ph in strisce
- cartine indicatrici ph in rotolo
- elettrodi di ph mettler
-
Manipolazione liquidi
-
Sicurezza
- Sicurezza
- armadi (vedere strumentazione)
- sicurezza individuale: occhi-viso
- sicurezza individuale: mani
- sicurezza individuale: vie respiratorie
- sicurezza individuale: udito
- sicurezza individuale: varie
- pronto soccorso e attrezzature per le emergenze
- contenitori per mat.pericolosi e disp. anti-radiazioni
- segnalazione
- igiene in laboratorio
-
Articoli sanitari
-
Miscellanea
- Miscellanea
- anelli diversi
- carta e navicelle per pesate
- cronometri e timer
- detergenti per vetreria
- dispensatori
- grasso al silicone
- lenti d'ingrandimento
- parafilm, alluminio, pvc in pellicola
- palloni lattice
- pennelli
- pompette gomma
- tappi
- tappi rovesciabili
- tettarelle
- tubi
- vaschette alluminio
- prodotti speciali
-
Microscopia
-
Microbiologia
- Microbiologia
- analisi alimenti-acque
- analisi microbiologiche con membrana filtrante
- semina
- campionamento microbiologico
- chiusure per batteriologia
- flambatura in batteriologia
- sacchetti sterili e accessori per omogeneizzatori
- sacchetti per trasporto campioni
- sistema per anaerobiosi
- sterilizzazione
- valutazione del livello igienico superfici
- Analisi acque
- ORDINE RAPIDO
- IL CONSORZIO
- MARCHI
- NEWS & PROMOZIONI
- CONTATTI
TERRENI CROMOGENICI ENTEROCOCCHI
E.C.O.A.GAR (ENTEROCOCCUS CHROMOGENIC OTTAVIANI & AGOSTI AGAR) PIASTRE 55 MM
Cod: 14.7073.99
Effettua il login per visualizzare il prezzo
E.C.O. AGAR
(ENTEROCOCCUS CHROMOGENIC OTTAVIANI & AGOSTI AGAR)
E.C.O.A.GAR (ENTEROCOCCUS CHROMOGENIC OTTAVIANI & AGOSTI AGAR) PIASTRE 55 MM
Scheda tecnica
- Tipo
- piastre 55 mm
- Confezione
- 30 piastre
Varianti
| Codice | Prodotto | Tipo | Confezione |
|---|---|---|---|
| polvere | 500 g | ||
| piastre 55 mm | 30 piastre |
Prodotti simili
ENTEROBACTERIACEAE ED ESCHERICHIA COLI
SENECA BASE POLVERE
Tipo: polvere
Confezione: 500 g
ESCHERICHIA COLI O157
CHROMOGENIC E.COLI O157 AGAR POLVERE
Tipo: polvere
Confezione: 500 g









